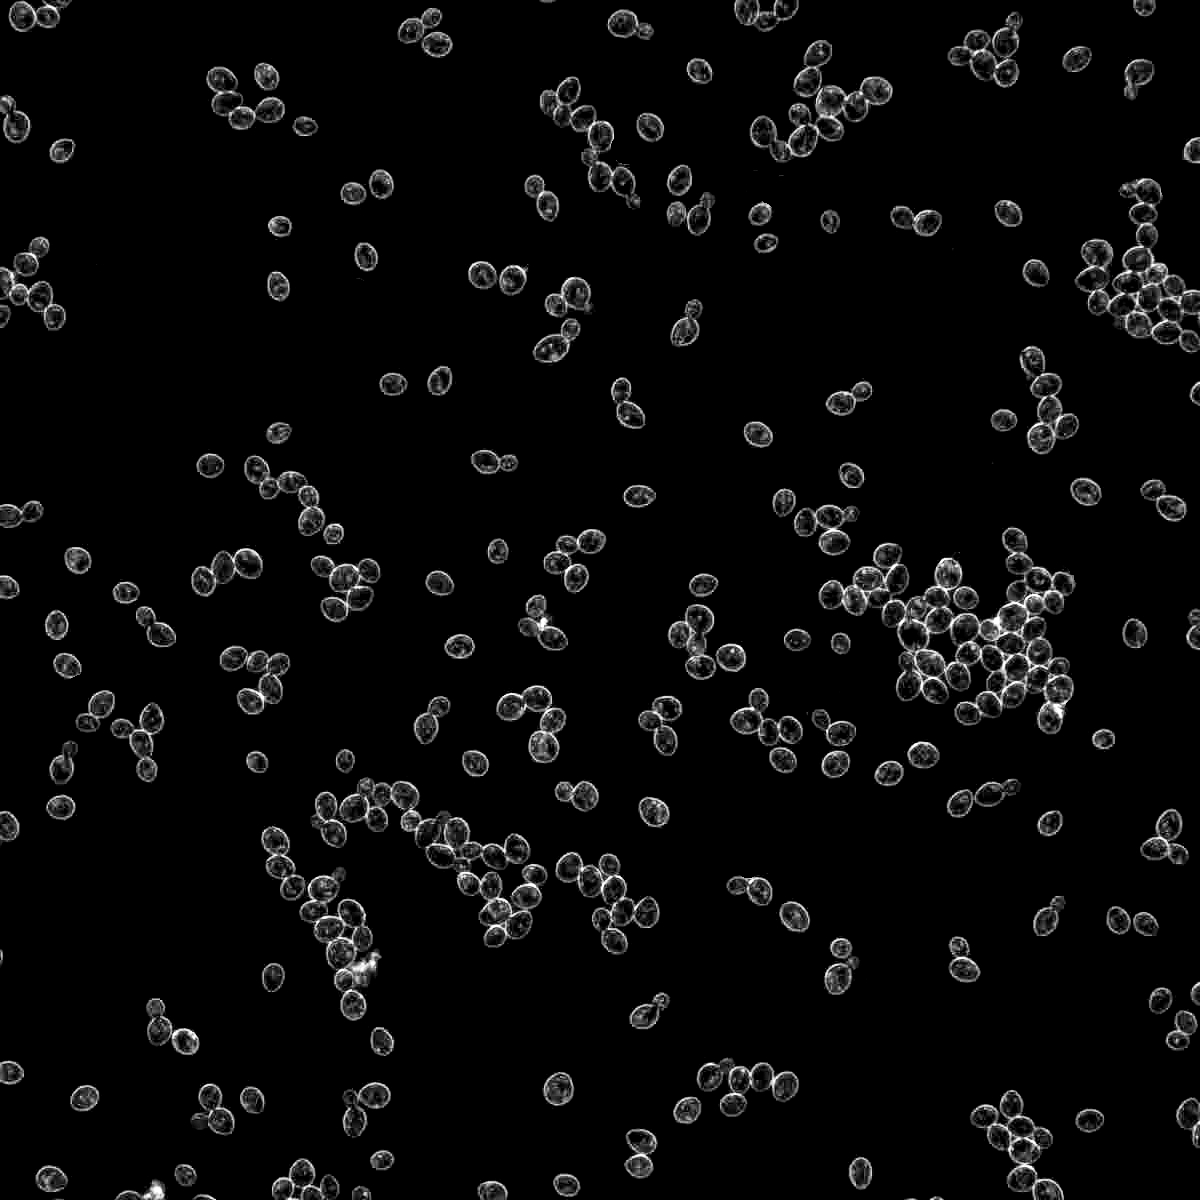
1056
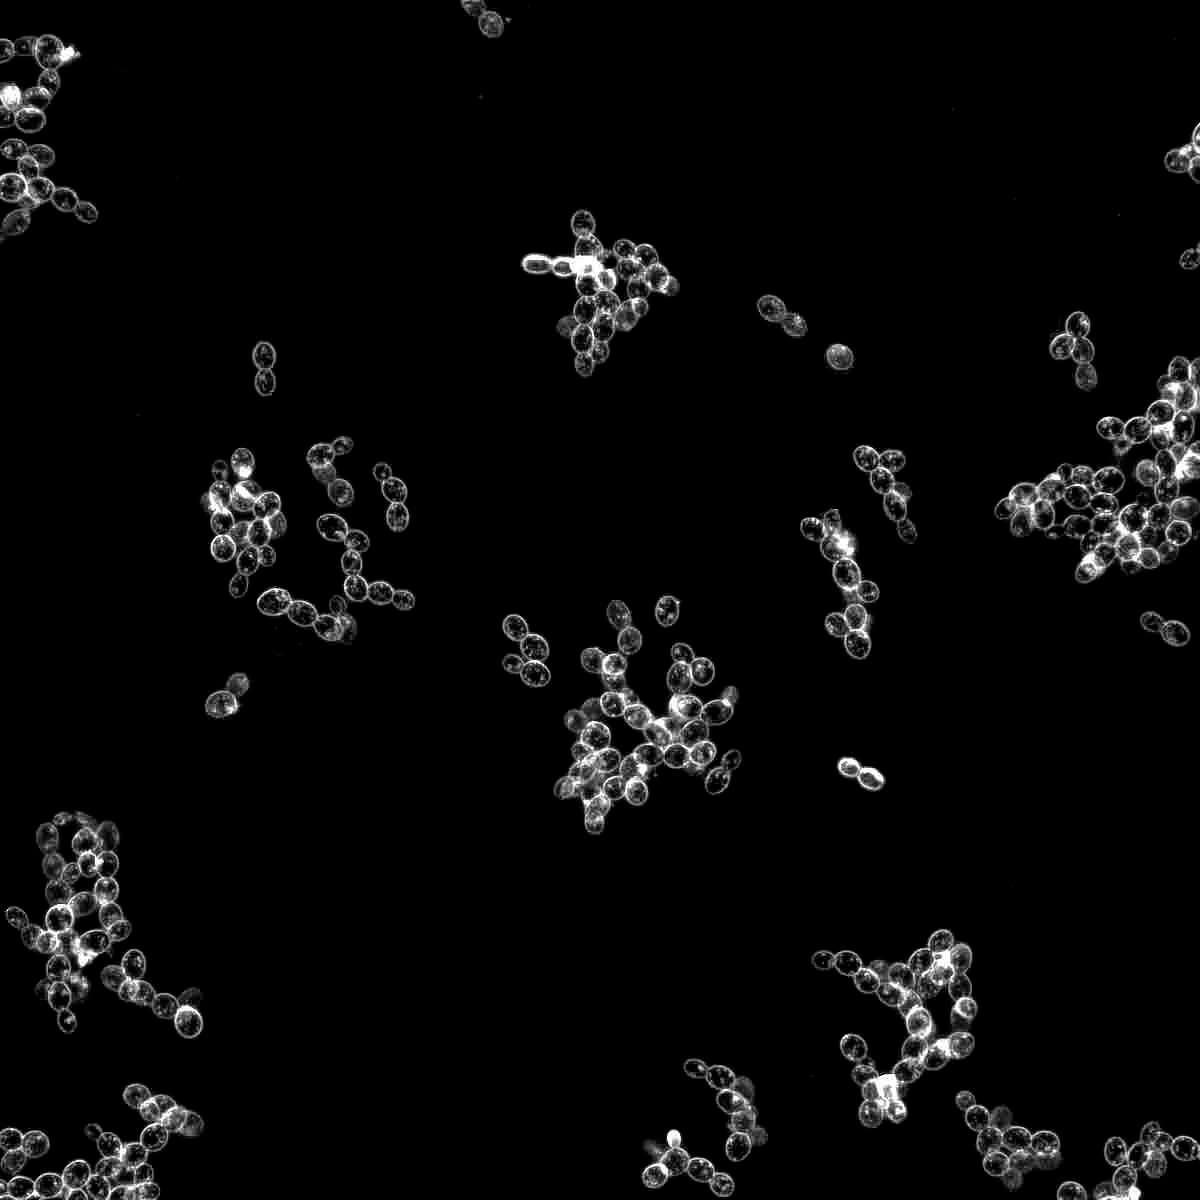
1332
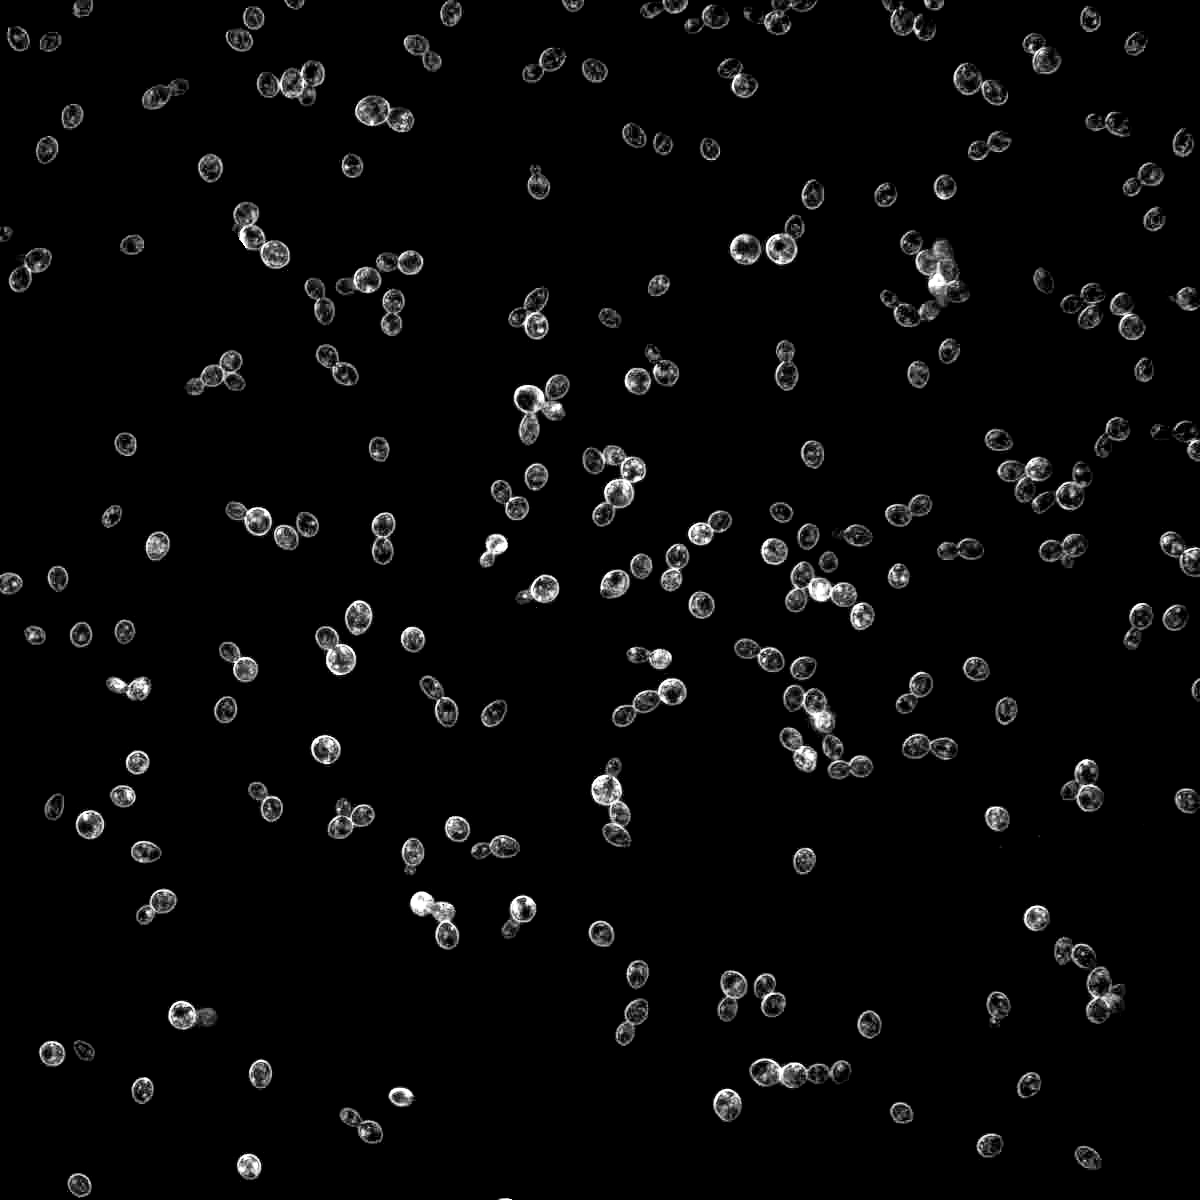
1450

1272

American Amber Ale
BJCP 19A
Amber and Brown American Beer
Overall Impression:
Deschutes Cinder Cone Red, Full Sail Amber, Kona Lavaman Red Ale, North Coast Ruedrich's Red Seal Ale, Rogue American Amber Ale, Tröegs HopBack Amber Ale
An amber, hoppy, moderate-strength American craft beer with a caramel malty flavor. The balance can vary quite a bit, with some versions being fairly malty and others being aggressively hoppy. Hoppy and bitter versions should not have clashing flavors with the caramel malt profile.
Commercial Examples:Deschutes Cinder Cone Red, Full Sail Amber, Kona Lavaman Red Ale, North Coast Ruedrich's Red Seal Ale, Rogue American Amber Ale, Tröegs HopBack Amber Ale
*The Style Name, Overall Impression, and Commercial Examples are borrowed with permission from the BJCP.
Scroll down